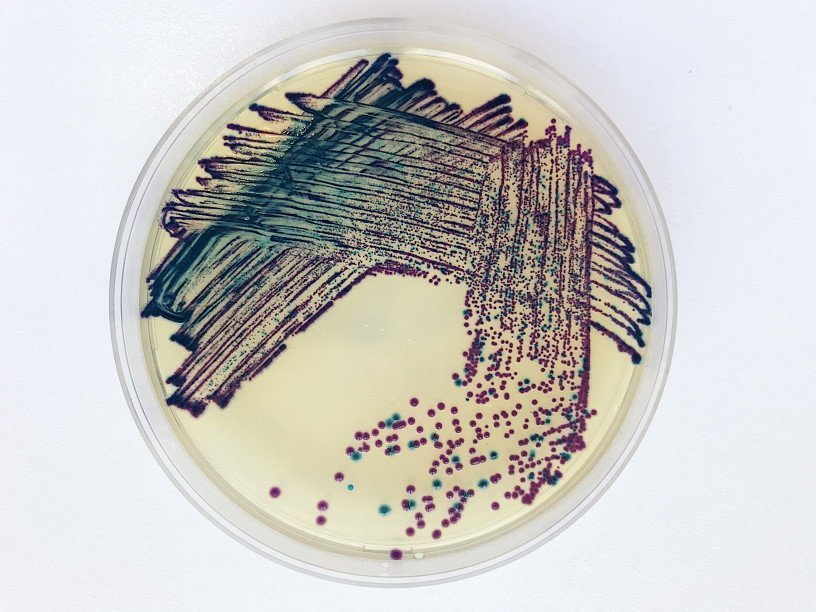

Екатерина Беленко: Промикробы: Жгутик — не роскошь
Klebsiella pneumoniae и Escherichia coli в чашке Петри Фото: Екатерина Беленко Антропоцентризм не позволяет нам в полной мере осознать, что такие крохотные существа, как бактерии, могут делать что-нибудь еще, кроме как лежать на полу. А ведь многие бактерии могут двигаться, что не так-то просто, если ты одноклеточный, и у тебя даже ядра нет. Приходится идти на микроскопические ухищрения. К ленивым и неподвижным бактериям относятся все кокки и некоторые палочки. Среди подвижных микробиков самым распространенным средством передвижения является жгутик, состоящий из белковых молекул.
У некоторых бактерий есть всего один жгутик, у других два жгутика располагаются на двух противоположных концах клетки, у третьих на полюсах клетки находятся пучки жгутиков, а у четвертых жгутики покрывают всю поверхность клетки. У спирохет жгутик находится в периплазматическом пространстве между двумя мембранами. Клетки спирохет имеют характерную извитую форму, которая меняется при движении.
Какие виды движения обеспечивает жгутик? Если бактерия находится в жидкой среде, ей повезло, ведь жгутик отлично помогает плыть. Плавание — это, пожалуй, самый быстрый и эффективный способ передвижения в микромире. Причем бактерия может неплохо управлять своим движением, меняя направление вращения: вращение по часовой стрелке толкает клетку в направлении от жгутика, а против часовой стрелки — вслед за жгутиком. Получается, что жгутики бактерий по характеру работы подобны корабельному винту. Если клетка имеет много жгутиков, они при движении собираются в пучок, который образует своеобразный пропеллер.
Не все коту масленица, а бактериям — жидкие среды обитания. На поверхности твердых питательных сред двигаться куда сложнее, а для большинства вообще невозможно. Одним из немногих микроорганизмов, способных двигаться по чашке Петри, является протей. Это род грамотрицательных палочек, полностью покрытых жгутиками. У протея бывают две формы — подвижные и неподвижные. И вот та самая подвижная форма протея дает характерный ползучий рост в виде нежной вуали, затягивающий всю поверхность сплошным налетом без образования отдельных колоний. Эта суперспособность носит название «феномен роения».
Это очень усложняет процесс анализа, если на чашке Петри есть другие колонии. Например, посеяли мочу, а в ней два возбудителя. Мы должны обоих опознать и провести тест чувствительности к антибиотикам для каждого по-отдельности. Но если один из этих двоих протей, то он затянет пленкой и своего подельника — попробуй разлучи. Спасибо производителям питательных сред: они научились с помощью различных добавок подавлять роение протеев, чтобы те, как все нормальные микробы, образовывали отдельные колонии. Протей не очень фотогеничен, поэтому на фотографии разделение двух слившихся в экстазе культур, но ни одна из них не протей. Это Klebsiella pneumoniae и Escherichia coli.
Смотрите также: Екатерина Беленко Промикробы: Зона комфорта Екатерина Беленко Промикробы: Красная и синяя таблетки Екатерина Беленко Промикробы: Скрытые фигуры Екатерина Беленко Промикробы: Кровь и пептон